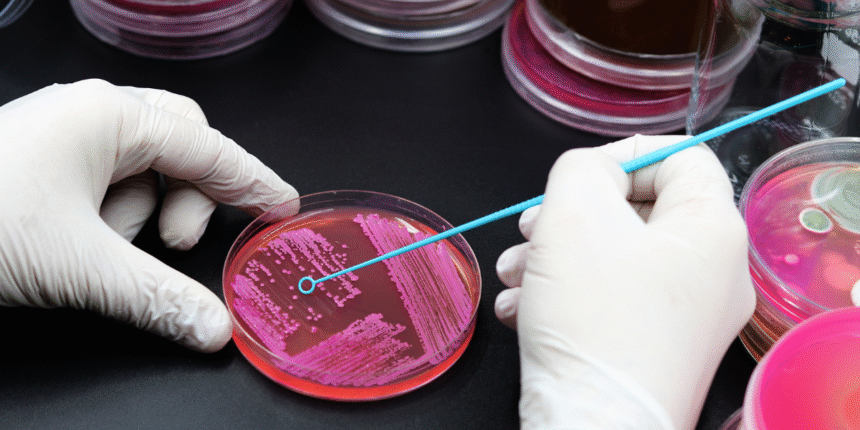
Urban Microbiome and Human Immunity: How City Life Shapes Your Gut and Skin Health

City Life Shapes Your Gut and Skin Health
Urbanization has changed how humans interact with the natural world. While modern cities offer convenience and safety, they also alter the microbial landscapes our bodies depend on. This hidden shift—known as the urban microbiome effect—is now recognized as a major factor in immunity, skin balance, and even mental health.

What Is the Urban Microbiome?
The urban microbiome refers to the collection of microorganisms that thrive in city environments—on surfaces, in the air, and on human bodies. Unlike rural microbiomes, which are diverse and heavily influenced by soil, plants, and animals, urban microbes often come from indoor spaces, synthetic materials, and human-to-human contact.
How City Living Affects Gut Health
- Reduced microbial diversity:
City dwellers are exposed to fewer types of beneficial bacteria, leading to a less resilient gut ecosystem. - Processed food diets:
High sugar and low fiber intake feed harmful gut bacteria. - Antimicrobial overuse:
Sanitizers, antibiotics, and treated water reduce beneficial microbes. - Stress and pollution:
Chronic stress and air pollutants disrupt gut-brain communication and increase inflammation.
The Skin Microbiome Connection
Urban air pollution and reduced contact with natural elements affect the skin’s microbial barrier.
- Fine particulate matter (PM2.5) fosters oxidative stress and microbial imbalance.
- Frequent washing and chemical exposure strip protective bacteria.
- Lack of soil-based organisms weakens skin immunity, increasing eczema and acne prevalence.
Why It Matters for Immunity
A diverse microbiome “trains” the immune system to distinguish between real threats and harmless triggers. When diversity declines:
- Allergies and autoimmune conditions rise.
- The immune response becomes overactive or underdeveloped.
- Inflammation persists, affecting overall vitality.
How to Reconnect with Microbial Diversity
- Spend time in nature: Contact with soil, plants, and animals restores microbiome variety.
- Eat prebiotic and probiotic foods: Yogurt, kefir, kimchi, and high-fiber vegetables feed beneficial bacteria.
- Limit over-sanitization: Clean safely, but avoid excessive use of antibacterials at home.
- Grow indoor plants: They increase microbial exchange and improve air quality.
- Choose whole foods: Minimally processed diets support microbial stability and immunity.
The Future of Urban Health
Researchers are exploring “microbial urban planning”—designing cities with green spaces, natural ventilation, and microbial diversity in mind. Schools, hospitals, and offices could one day be designed to promote microbial exposure rather than eliminate it.
Conclusion
City life doesn’t have to mean a weaker immune system. By embracing urban biodiversity and mindful living, residents can balance modern comfort with biological resilience. The microbes around us aren’t enemies—they’re essential allies in human health.